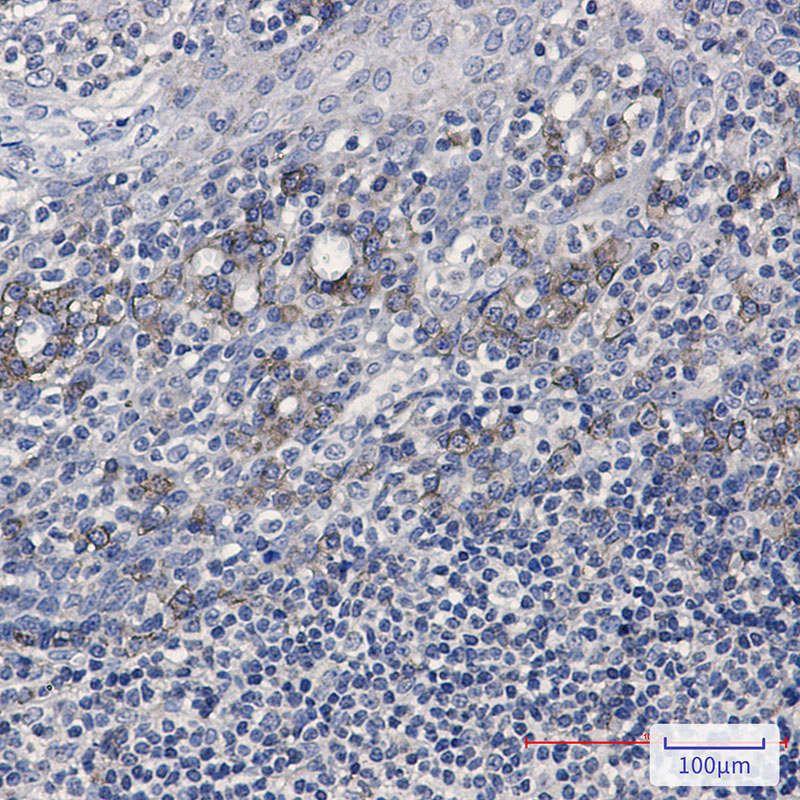

-
分类: 科研抗体货号: P20846别名: CDC46; MCM5; MGC5315; P1 CDC46应用: WB,IP,IHC,IF反应种属: Human,Rat
-
分类: 科研抗体货号: P20844别名: importin 9; Imp9; Ran-binding protein 9; RanBP9应用: WB,IP,IF反应种属: Human
-
分类: 科研抗体货号: P20860别名: p68; p70; ANX6; CBP68; CPB-II应用: WB,IP,IHC,IF反应种属: Human,Rat
-
分类: 科研抗体货号: P20843别名: Transcription initiation factor TFIID subunit 3应用: WB,IHC反应种属: Human
-
分类: 科研抗体货号: P20876别名: ABC38; ABCE1; HuHP68; OABP; RLI; RNASEL1; RNASELI; RNS4I应用: WB,IP反应种属: Human,Mouse,Rat
-
分类: 科研抗体货号: P20859别名: TS11; ASNSD; ASNS; Asparagine synthetase [glutamine-hydrolyzing]应用: WB,IHC反应种属: Human,Rat
-
分类: 科研抗体货号: P20841别名: Fc fragment of IgG; low affinity IIb; receptor (CD32); CD32; FCG2; CD32B; FCGR2; IGFR2应用: WB,IHC反应种属: Human,Rat
-
分类: 科研抗体货号: P20875别名: EIF2AK2; PKR; PRKR; Interferon-induced; double-stranded RNA-activated protein kinase; Eukaryotic translation initiation factor 2-alpha kinase 2; eIF-2A protein kinase 2; Interferon-inducible RNA-dependent protein kinase; P1/eIF-2A protein k应用: WB,IP,IHC,IF反应种属: Human
-
分类: 科研抗体货号: P20858别名: hFL(2)D; WT1-associated protein; Wilms tumor 1-associating protein; Pre-mRNA-splicing regulator WTAP应用: WB,IP,IHC反应种属: Human
-
分类: 科研抗体货号: P20840别名: Gnb2; Gnb2l1; RACK1; Transducin beta chain 2应用: WB,IP,IHC反应种属: Human,Mouse,Rat

鄂公网安备42018502007531号
鄂公网安备42018502007531号

